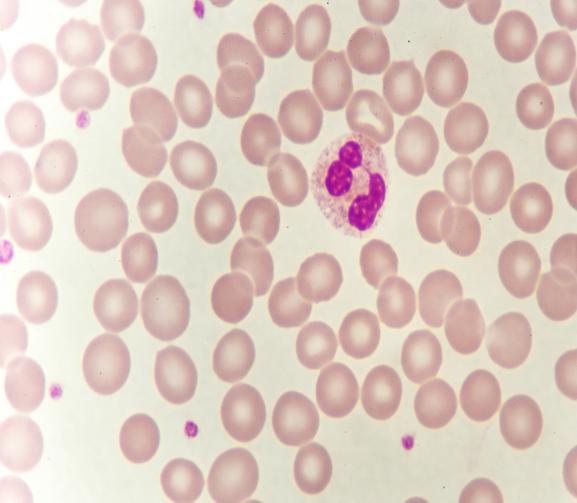
中性粒细胞胞
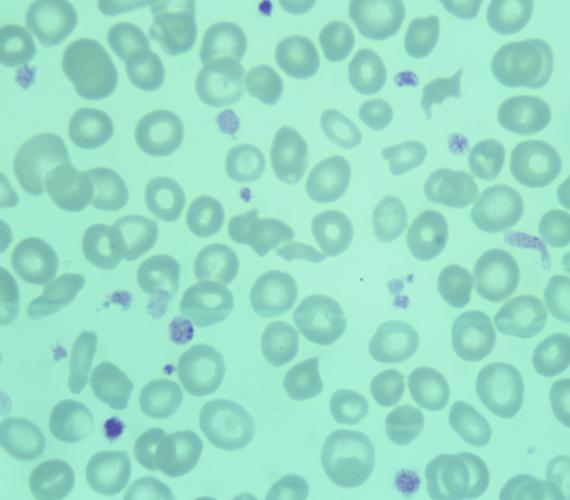
0015(55)

在医疗急救中常用到袋装的橙黄色液体比黄金还要珍贵,就是血液成份里的血小板,今天带大家深度认识一下人体的“止血卫士”——血小板。
(一)从哪里来?
血小板(Platelets,PLT)是从骨髓中成熟的巨核细胞胞浆中脱落下来的小块胞质,单个血小板成透明色。血小板是人体最小的细胞,平均直径2-4μm,数量一般(100-300)×10^9/L。
(二)血小板功能
血小板主要职责是止血,当身体受损伤,血管破裂出血时,血小板会聚集到伤口处,形成血栓,堵住伤口。此外血小板还参与炎症与免疫反应。
(三)血小板检测临床意义
血小板减少的常见原因
1、药物引起 脑梗或者心脏支架患者使用的抗血小板聚集药物如替罗非班,其他药物如哌拉西林唑巴坦、甲硝唑也可引起血小板减少。
2、感染和炎症 体内免疫功能紊乱,免疫细胞攻击血小板;免疫细胞分泌的炎性因子刺激血管壁,导致血小板消耗。
3、血液系统疾病 血小板生成减少
1)造血干细胞病变 再生障碍性贫血。
2)疾病浸润骨髓,破坏造血环境和造血干细胞,如白血病、多发性骨髓瘤、骨髓转移癌、骨髓纤维化。
3)血小板无效生成,特征为骨髓巨核细胞增多,而血小板更新下降,如巨幼细胞性贫血、骨髓增生异常综合征、部分缺铁贫,红白血病。
4)血小板破坏增多如血栓性血小板减少性紫癜,一种罕见的微血管血栓—出血综合征。
4、肝病和脾功能亢进 肝硬化时循环免疫复合物沉积于血小板表面引起血小板自身性溶解,同时免疫复合物也可沉积与造血干细胞表面,血小板生成减少;继发性脾功能亢进,导致血小板破坏过多。
5、EDTA依赖性假性血小板减低(假性)EDTA诱导血小板中特殊蛋白使血小板发生聚集。
6、血小板卫星现象(假性)血小板粘附在成熟中性粒细胞周围呈卫星状分布。
7、采血不当(假性)采血时间过长、采血后未及时混匀、采血量与抗凝剂比例不当。
8、冷凝集现象(假性)凝集反应有时也发生在室温下。
9、巨大血小板(假性)病理情况下,大血小板甚至巨血小板增多,仪器误记为红细胞。
血小板升高的常见原因
骨髓增值性疾病,如原发性血小板增多症,慢性粒细胞白血病
血小板假性升高的因素
1、严重烧伤患者可导致红细胞发生溶血,溶血破坏的红细胞碎片以及变形的红细胞可干扰血小板的计数,造成假性增高,此时宜纠正计数。
2、缺铁性贫血属于小细胞性贫血,红细胞的体积较小且具有不均一性,有较多数量的红细胞直径<6nm,小红细胞可导致血小板的假性增高,且此影响随MCV逐渐减小,RDW的不断升高而加剧。
3、脂肪乳剂中的个别脂肪乳颗粒直径(<1%)和患者血小板相近,可导致血小板计数假性增高,建议在输用脂肪乳后5-6小时以后进行血常规检测。
4、冷球蛋白是一种含有类风湿因子和单克隆或多克隆免疫球蛋白,在低温(0-4°C)时易沉淀而在37°C时可再溶解的病理性免疫球蛋白。患者血常规标本中形成的冷沉淀颗粒可能使血细胞分析仪将小冷沉淀颗粒归为血小板,导致PLT假性增多。
5、体内存在细菌可能也会引起血小板假性升高,研究发现马尔尼菲篮状菌大小为2~8um,与血小板大小相近,同时菌体内也含有核酸物质,误把马尔尼菲篮状菌当作血小板而计数。
(四)血小板数量正常就正常吗?
血常规报告主要显示血小板数量,平均大小相关项目,大多数人认为血小板数量正常就是正常的,大家看右侧的图片是骨髓增生异常综合征(MDS)病人的血液涂片,涂片中血小板数量未见减少,但是血小板大小不等,染色较浅,颗粒缺失,这些都是没有正常功能的血小板。
(五)检查血小板功能的相应项目
如果病人有长期服用抗血小板药物或者慢性肾功能不全、尿毒症、多发性骨髓瘤、骨髓增殖性疾病或者先天性异常的疾病除了检测血常规外,还有科选择相应的其他项目:血小板聚集实验、血小板黏附实验、凝血检测以及我院检验科开展的血栓弹力图检测。